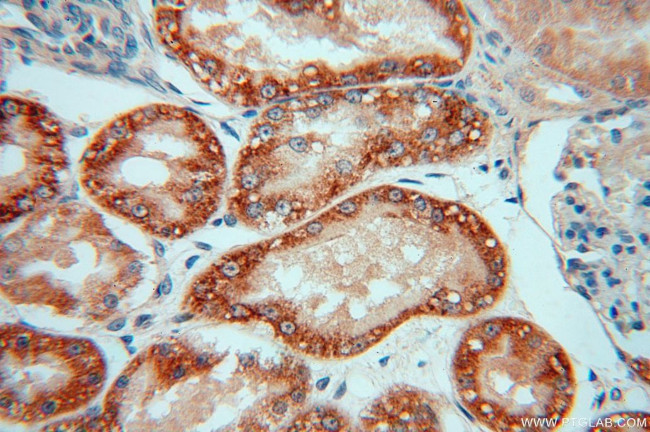
NDUFAF1 Antibody in Immunohistochemistry (Paraffin) (IHC (P))

Search
Proteintech
NDUFAF1 Polyclonal Antibody
{{$productOrderCtrl.translations['antibody.pdp.commerceCard.promotion.promotions']}}
{{$productOrderCtrl.translations['antibody.pdp.commerceCard.promotion.viewpromo']}}
{{$productOrderCtrl.translations['antibody.pdp.commerceCard.promotion.promocode']}}: {{promo.promoCode}} {{promo.promoTitle}} {{promo.promoDescription}}. {{$productOrderCtrl.translations['antibody.pdp.commerceCard.promotion.learnmore']}}
产品信息
15181-1-AP
种属反应
已发表种属
宿主/亚型
分类
类型
抗原
偶联物
形式
浓度
规格
纯化类型
保存液
内含物
保存条件
运输条件
产品详细信息
Immunogen sequence: MALVHKLLR GTYFLRKFSK PTSALYPFLG IRFAEYSSSL QKPVASPGKA SSQRKTEGDL QGDHQKEVAL DITSSEEKPD VSFDKAIRDE AIYHFRLLKD EIVDHWRGPE GHPLHEVLLE QAKVVWQFRG KEDLDKWTVT SDKTIGGRSE VFLKMGKNNQ SALLYGTLSS EAPQDGESTR SGYCAMISRI PRGAFERKMS YDWSQFNTLY LRVRGDGRPW MVNIKEDTDF FQRTNQMYSY FMFTRGGPYW QEVKIPFSKF FFSNRGRIRD VQHELPLDKI SSIGFTLADK VDGPFFLEID FIGVFTDPAH TEEFAYENSP ELNPRLFK (1-327 aa encoded by BC000780)
靶标信息
The NDUFAF1 gene encodes the human homolog of a Neurospora crassa Cia30 protein involved in the assembly of complex I.
仅用于科研。不用于诊断过程。未经明确授权不得转售。
生物信息学
蛋白别名: Complex I intermediate-associated protein 30, mitochondrial; NADH dehydrogenase (ubiquinone) 1 alpha subcomplex, assembly factor 1; NADH dehydrogenase (ubiquinone) 1 assembly factor 1; NADH dehydrogenase (ubiquinone) complex I, assembly factor 1; NADH dehydrogenase [ubiquinone] 1 alpha subcomplex assembly factor 1; NADH-ubiquinone oxidoreductase 1 alpha subcomplex, assembly factor 1
基因别名: 2410001M24Rik; CGI-65; CGI65; CIA30; MC1DN11; NDUFAF1
UniProt ID: (Human) Q9Y375, (Mouse) Q9CWX2
Entrez Gene ID: (Human) 51103, (Rat) 296086, (Mouse) 69702